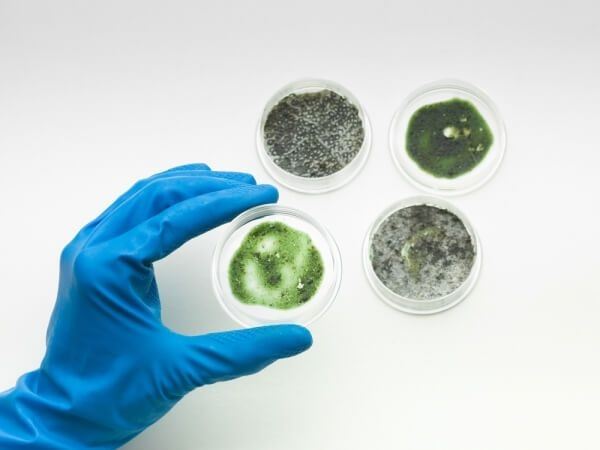
mold identification

Most people have heard of Stachybotrys chartarum, aka the notorious black mold. Known for being toxic at high levels of exposure, homeowners can usually identify this type of mold by its dark, spotty appearance. But what do you do if black mold is hiding in your house? Fortunately, there is a way to identify black mold without seeing it: the smell. What does black mold smell like? Keep reading for everything you need to know, and remember that for all your mold remediation, inspection, and testing needs, you can always count on our licensed professionals at FP Property Restoration.
How to Identify the Odor of Black Mold
The odor of black mold is strong enough that you can often identify it before the mold growth itself even becomes visible. Known for being found in dark, dank places like many other kinds of molds, black mold has a strange musty odor—definitely not a pleasant scent for human nostrils. Some people have compared this smell to that of rotting wood or paper, while others have said it smells like cedar. Many have also likened it to the smell of dirty socks. You’ve probably detected a similar odor at some point; think about when you are in the gym, and you encounter that wet, stale smell in the locker room.
The reason that many of these odors are similar is because of moisture. Moisture is the driving force in creating mold, including Stachybotrys chartarum. You can air out a room to get rid of this smell, but unfortunately, this is more of a preventative measure. Limiting moisture in your home is important, but once black mold has started to grow, that smell is not likely to go away on its own, even if it is just concentrated in one room. Unfortunately, people often become accustomed to the odors they are around fairly quickly, which is why many homeowners do not begin the mold remediation process until the problem is severe. That’s why it is important to watch out for this smell—even before it appears! Black mold spores can cause breathing problems and sneezing before an odor can be detected, so again, make sure to be vigilant if you do not want to deal with this nasty substance.
Call FP Property Restoration for All Your Mold-Related Needs
In some cases, you may be able to get rid of black mold on your own by scrubbing it away with a wire brush, disposing of the residue in a tightly sealed bag, vacuuming the spot of the growth to eliminate lingering spores, and isolating that room from the rest of your house. You can also get rid of smaller amounts of mold with bleach, although it is essential to thoroughly dry any affected area after cleaning so the mold does not return. However, in most cases, it is better to hire a professional to get rid of black mold. To reiterate, this substance is extremely toxic, especially for those with allergies, asthma, or other respiratory issues. That’s why at FP Property Restoration, our process is designed to eliminate mold growth completely. We know how to take care of black mold stemming from water and storm damage, as well as virtually any other cause. Call now to learn more, and don’t let black mold affect your life!
FP Property Restoration is available by phone at (888) 408-2335, or you can contact us online.